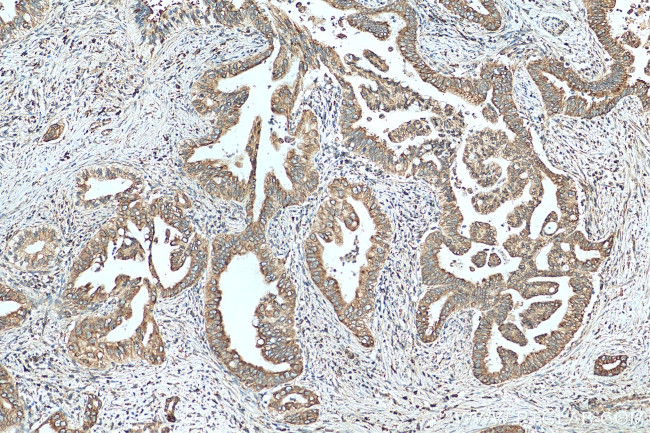
UGCGL1 Antibody in Immunohistochemistry (Paraffin) (IHC (P))

Search
Proteintech
UGCGL1 Polyclonal Antibody
{{$productOrderCtrl.translations['antibody.pdp.commerceCard.promotion.promotions']}}
{{$productOrderCtrl.translations['antibody.pdp.commerceCard.promotion.viewpromo']}}
{{$productOrderCtrl.translations['antibody.pdp.commerceCard.promotion.promocode']}}: {{promo.promoCode}} {{promo.promoTitle}} {{promo.promoDescription}}. {{$productOrderCtrl.translations['antibody.pdp.commerceCard.promotion.learnmore']}}
产品信息
14170-1-AP
种属反应
宿主/亚型
分类
类型
抗原
偶联物
形式
浓度
规格
纯化类型
保存液
内含物
保存条件
运输条件
产品详细信息
Immunogen sequence: TEEVKQDKD DIINIFSVAS GHLYERFLRI MMLSVLKNTK TPVKFWFLKN YLSPTFKEFI PYMANEYNFQ YELVQYKWPR WLHQQTEKQR IIWGYKILFL DVLFPLVVDK FLFVDADQIV RTDLKELRDF NLDGAPYGYT PFCDSRREMD GYRFWKSGYW ASHLAGRKYH ISALYVVDLK KFRKIAAGDR LRGQYQGLSQ DPNSLSNLDQ DLPNNMIHQV PIKSLPQEWL WCETWCDDAS KKRAKTIDLC NNPMTKEPKL EAAVRIVPEW QDYDQEIKQL QIRFQKEKET GALYKEKTKE PSREGPQKRE EL (1221-1531 aa encoded by B C041098)
靶标信息
UDP-glucose:glycoprotein glucosyltransferase (UGGT) is a 170 kDa lumenal endoplasmic reticulum (ER) resident protein that catalyzes monoglucosylation of high mannose oligosaccharides. UGGT catalyzes the transfer of glucose from UDP-glucose to Man7-9GlcNAc2-moiety of unfolded glycoproteins in a Ca2+ dependent reaction. UGGT binds unfolded glycoprotein via two elements on its substrate: a N-acetylglucosamine unit on the oligosaccharide and hydrophobic amino acids that are exposed in the denatured conformation. It is postulated that UGGT serves as a sensor that is able to distinguish between folded and denatured protein in the ER.
仅用于科研。不用于诊断过程。未经明确授权不得转售。
生物信息学
蛋白别名: HUGT1; RUGT; UDP--Glc:glycoprotein glucosyltransferase; UDP-glucose ceramide glucosyltransferase-like 1; UDP-glucose glycoprotein: glucosyltransferase UGGT; UDP-glucose:glycoprotein glucosyltransferase; UDP-glucose:glycoprotein glucosyltransferase 1; UGT1; unnamed protein product
基因别名: 0910001L17Rik; A930007H10Rik; AA589501; AI414429; AI448372; C820010P03Rik; GT; HUGT1; rUGT1; UGCGL1; UGGT; UGGT1; UGT1; UGTR
UniProt ID: (Human) Q9NYU2, (Rat) Q9JLA3, (Mouse) Q6P5E4
Entrez Gene ID: (Human) 56886, (Rat) 171129, (Mouse) 320011